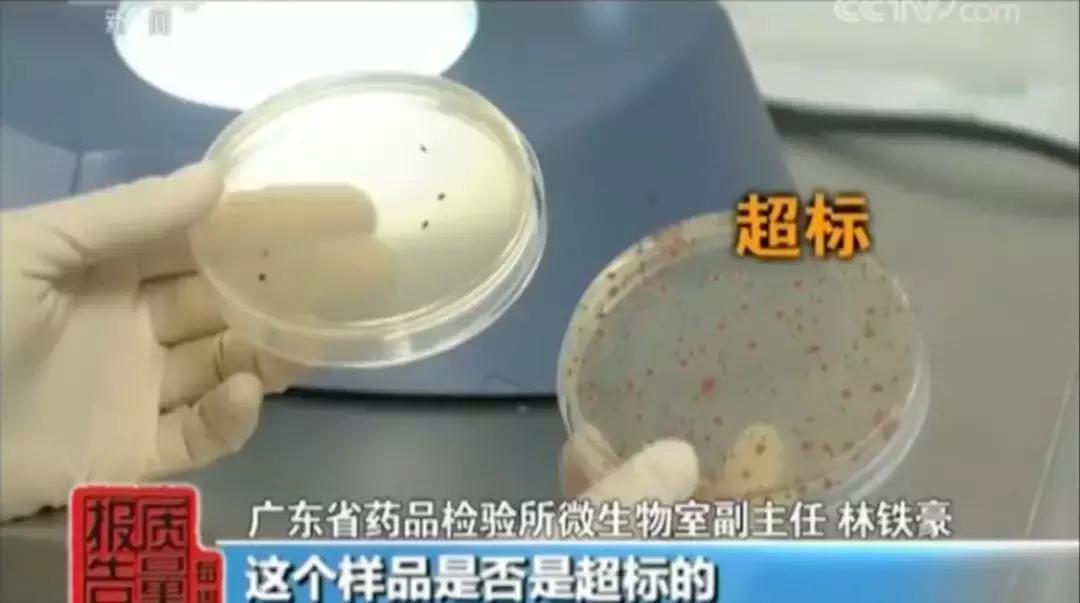
央视曝光的27款不合格面膜,央视报道面膜有哪些

知道大家都在过节,所以今天的内容我们直奔重点,昨晚区花正在网上冲浪时,看到一个特别扎眼的标题上了热搜,那就是“27批次不合格面膜”。

哎呀妈呀这还了得,于是拥有与生俱来揭黑嗅觉的我,迅速点开了标题get了重点,并写下了这篇文章...
幸运的是这些不合格的面膜有90%我都没听过,不是三无就是微商,不幸的是他们对皮肤甚至身体健康造成影响不容小觑。

思来想去还是要总结一波,万一真的有人在用,或者你身边的人有在用呢?首先来看看都有哪些菌落总数超标的面膜,不过在这之前得先解释下...
菌落总数是什么
菌落其实就是我们常说的细菌,菌落总数则是一个卫生指标,它反映了产品的卫生情况。

就是指在一定条件下,每克或每毫升的检测样品,所生长出来的细菌菌落总数。比如经过48小时的培养后,原本什么都看不见的平板上,出现了肉眼可见的菌落形态,如图所示。

合格的面膜经过菌落培养后应该是左边的状态,不合格的则是右边的状态,写这段时我的密集恐惧症都要犯了,是真的恶心...想想这样的面膜敷在脸上,皮肤能好了么?
而且,如果这些菌落是致病菌,恰巧你的脸上有些细微的伤口,敷了超标菌落面膜后就很有可能将致病菌透过伤口带进皮肤,从而影响身体健康。
如果这些菌落只是单纯的细菌,那么则会造成皮肤敏感、屏障受损。不管哪种都是百害无一利的。

以下是菌落超标面膜清单,最少的超标20倍,最高的超标7200倍。快看看有没有你认识的面膜吧...
台湾森田保湿精华水嫩面膜

茜茜雨露熊果苷雪颜亮肤面膜

茜茜雨露洋甘菊舒缓调理面膜

茜茜雨露备长碳净颜水润黑金面膜

沁颜芯鲜润•复活草瞬透沁润补水面膜

水盈七子白水分缘面膜

谷幽兰净白面膜

美丽习惯从容美白面膜

玉颜面膜一号和玉颜面膜二号

婴国天使婴儿蚕丝面膜(超标1000倍)

珀微蓝莓嫩肤细致面膜

名蔻玻尿酸水漾透亮双层面膜

若泉水磁场立润保湿蚕丝面膜

纤之恋倍润修护丝滑海藻面膜

纤之恋雪肌亮肤补水海藻面膜

海洋传说补水透白面膜

海洋传说深海鱼油高倍水润面膜

还有几款面膜区花没有找到图,分别是城市物语备长炭深层清洁黑膜、竹炭纤维保湿紧致面膜、比比兔备长炭清爽保湿面膜...

当然不合格面膜的还远不止菌落总数超标这一个危害。比如很多美容院会给顾客推荐面膜,都声称自己是纯植物,纯草本,使用后皮肤各种水润亮白,并且这种面膜在市面上很难买到(实际上是不知道从来进来的货,然后自己搞了个牌子)。

消费者鬼使神差买回了家,刚开始用的确如美容院所说,见效飞快,可一旦停用几天后,脸上就开始出现蜕皮和敏感的症状,实际上是面膜中添加了糖皮质激素。

说起糖皮质激素区花之前有专门写过一篇文章讲它,实际上就是我们所说的激素脸,没看过的宝宝戳

比起郑爽和倪妮的烂脸史,更可怕的是...
简单来说如果使用了含糖皮质激素的护肤品后,短期内可以收缩毛细血管,比如有些皮肤泛红的宝宝一下子好了,而且当皮肤吸收激素后,它会打破我们正常的水和钠代谢,令角质层含水量增加,外观上看起来皮肤水润饱满,实际上是烂脸前夕的肿胀。

在一般的情况下糖皮质激素属于医用范畴,多用于病情危重抢救,具有抗炎、抗过敏和抗休克的作用...

除非特殊情况,糖皮质激素不能长期使用,否则会带来很多的不良反应,比如面部浮肿、*疮痤**、高血压、高血脂,还可能诱发或加重糖尿病,致胎儿畸形。

同时糖皮质激素还有抑制的功效,最直接的就是抑制胶原蛋白合成,这样一来皮肤就会变薄,还会引起皮肤代谢下降,细胞活性受到抑制,皮肤就会越来越干,接着毛细血管扩张,开始出现干燥、脱屑、严重瘙痒、*血丝红**等症状,也就是我们常说的激素脸。

添加了糖皮质激素的面膜有...
膜法奇迹之补养面膜

静距离千颜蜜语桃花净颜靓肤面膜

纤美玻尿酸原液水润赋嫩蚕丝面膜

佐伊偌蚂蚁深层润白保湿神仙面膜

列了这么多面膜出来,我才发现,除了森田我一个都没听过,在此奉劝大家,不要买三无和微商!不要买三无和微商!不要买三无和微商!重要的事情说三遍!
如果是没听过的牌子可以先去“国家食品药品监督管理局网站”查一下备案,算我求求你们了!

最后希望市面上所有不合格的护肤、彩妆品赶紧消失的请点赞!